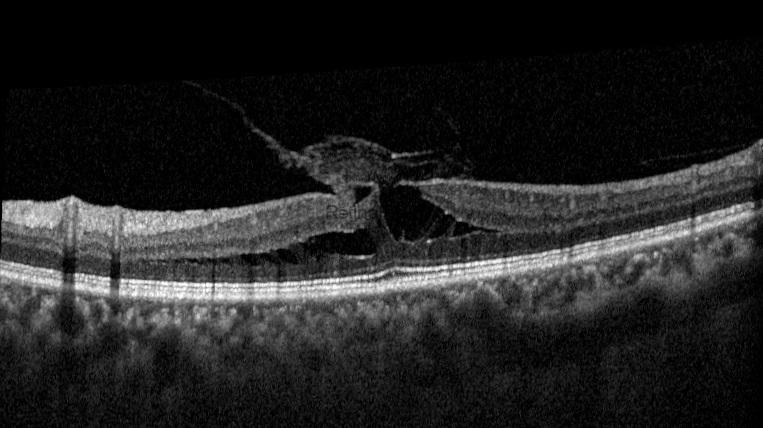
tractional-lamellar-macular-hole-preop-1-Kopya5iqI3Wt
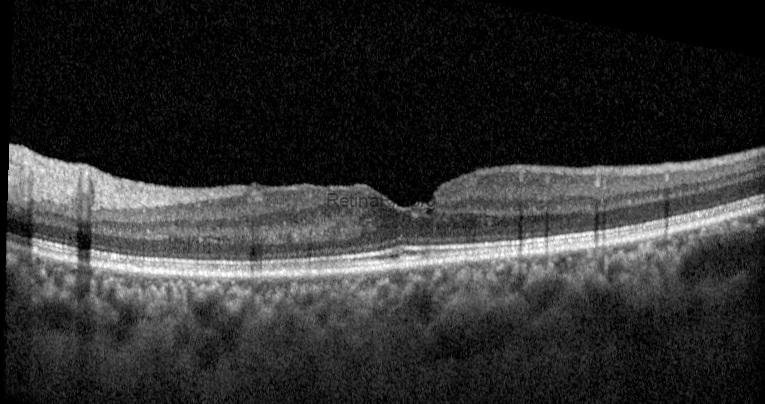
tractional-lamellar-macular-hole-postop-2
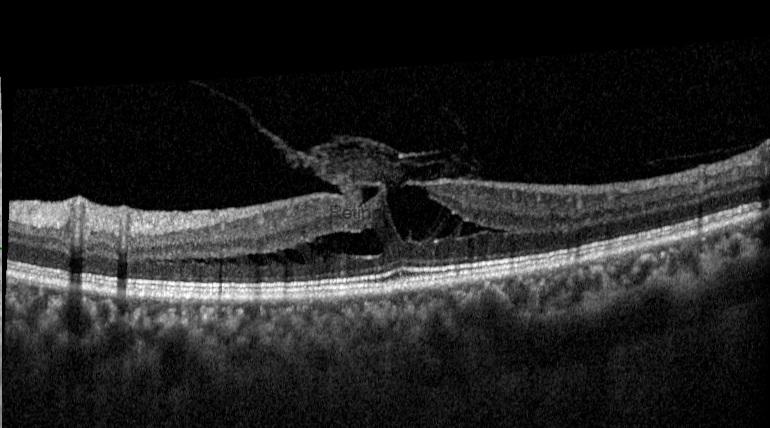

This post will present a Tractional Lamellar Macular Hole surgery. This is a 55-year-old female patient whose left visual acuity has been decreasing over the last 6 months. Her preoperative visual acuity was 20/100. OCT revealed a vitreomacular traction, a Tractional lamellar macular hole (LMH), a thin ERM at the edge of LMH, and a thick fibroglial tissue. The term tractional LMH has recently been changed to ERM-Foveoschisis. However, because the traction of the vitreous and fibroglial tissue on the fovea is the primary concern in this case, it would be more accurate to refer to it by the older term.
Preoperative multicolor image, autofluorescence image, and OCT of the patient with a tractional macular hole

The surgeon performed a combined vitrectomy with cataract surgery in this case. She used the Eibos 2 imaging system and the Dorc Eva faco-vitrectomy device. One month after surgery, foveoschisis or LMH disappeared, and a complete foveal depression occurred.

Credit: Ayşegül Mavi Yıldız, MD, FEBO, FICO, MRCSEd
Retina Göz Hastanesi, Bursa, Türkiye
Instagram account: @aysegul_md